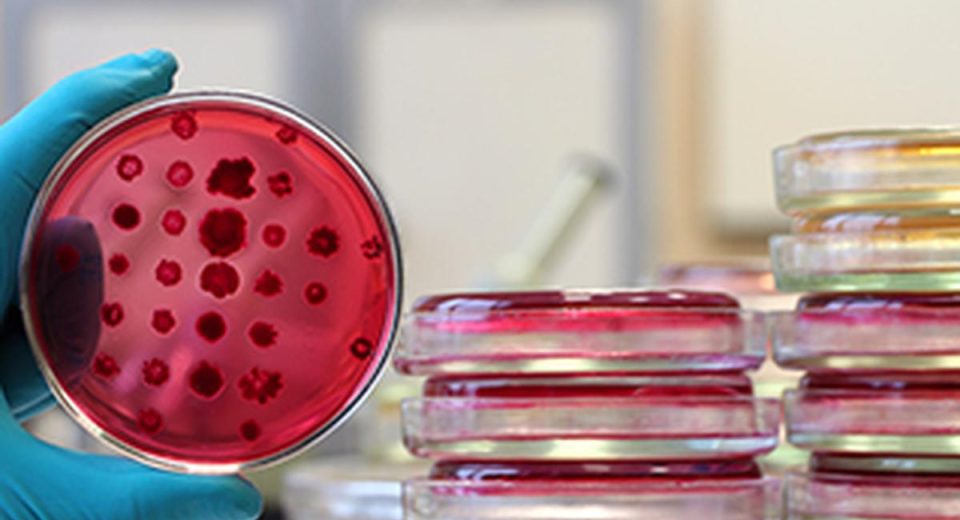

Milind Rege, Mumbai cricket stalwart, passes away at 76
Milind Rege, Mumbai cricket stalwart, passes away at 76 Former Mumbai captain Milind Rege – renowned as Mumbai cricket’s encyclopaedia – passed away on Wednesday at a hospital due to cardiac arrest. He was 76. An off-spinning all-rounder who featured in 52 First-Class matches during the golden age of Mumbai cricket, Rege was part of […]